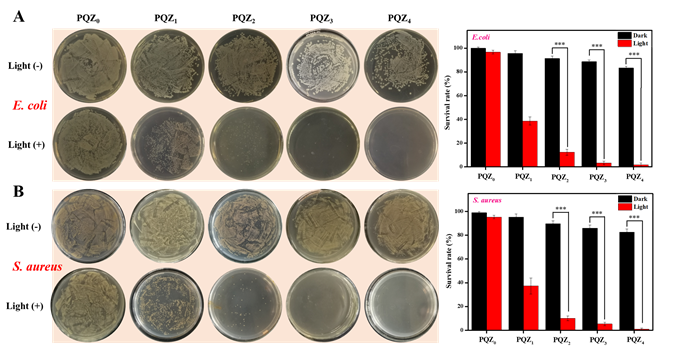

研究背景
食源性疾病被认为是全球一个严重的公共卫生问题。病原体污染和浮游微生物不受控制的生长是导致食品腐败的主要原因之一。食品包装是防止微生物污染的有效屏障,然而,在食品保存过程中,直接与食品接触的单一活性剂只表现出短暂的抗菌效果,不利于食品的长期保存。此外,不耐热、抗紫外线能力差或不安全的薄膜会将有害物质分解到食品中,不利于人们的健康。因此,开发具有高效杀菌、紫外线阻隔且稳定安全的多功能抗菌薄膜仍然是一个巨大的挑战。
抗菌光动力疗法(APDT)因其在高效杀菌并减少耐药性出现等方面优于传统抗生素而受到了研究人员的关注。光敏剂(PS)在APDT中是关键性因素,它在氧气存在下结合光照辐射可在细胞内产生细胞毒性活性氧(ROS)以消杀致病菌,为了提高抗菌活性,PS应该较多的进入微生物细胞。沸石咪唑酯骨架(ZIF-8)是一种具有良好生物相容性、高载药率和pH响应性释放药物的金属有机框架材料(MOFs),ZIF-8纳米载体可有效地将PS靶向运输至微生物细胞,故可将ZIF-8结合光动力疗法用于高效的细菌消杀并减少耐药性。
文章要点
针对难以开发具备多功能复合膜的问题,澳门六合彩开奖查询网站
王萃娟课题组通过将金属有机框架与抗菌光动力疗法相结合的策略,制备了一种基于ZIF-8的新型多功能抗菌复合薄膜。将光敏剂孟加拉红(RB)在室温通过一锅法包封至ZIF-8中,得到RB@ZIF-8 NPs。在以聚(ε-己内酯)(PCL)和聚乙烯醇-季铵盐壳聚糖(PVA-QCS)为基质的薄膜中掺杂SiO2和RB@ZIF-8 NPs,以形成具有光动力杀菌的PQZ复合膜(图 1)。

图 1 PQZ复合膜的制备及抗菌示意图
研究发现,PQZ复合膜在抗菌实验中表现出优异的光动力抗菌活性和良好的抗细菌粘附性(图 2),并且PQZ复合膜具有良好的机械性能,拉伸强度可达43.4 MPa,约PCL薄膜的1.8倍。此外,SiO2和RB@ZIF-8 NPs的添加,使复合膜具有良好的防水性和紫外阻隔性。在细胞实验中PQZ复合膜呈现较低的细胞毒性,对细胞的生长和繁殖没有明显的抑制作用。
图 2 菌种在复合膜上的存活率,(A)大肠杆菌,(B)金黄色葡萄球菌
综上,本研究将ZIF-8和抗菌光动力疗法相结合,扩大了ZIF-8的应用范围,为进一步设计合理的抗菌薄膜提供了新思路,PQZ多功能复合膜将作为包装材料有望应用于食品领域。相关成果以“UV-blocking and light-responsive poly (ε-caprolactone) /ZIF-8 multifunctional composite films for efficient antibacterial activities”为题发表在TOP期刊Chemistry - A European Journal(DOI: 10.1002/chem.202300785)。该项工作得到国家自然科学基金(No.21401151)、四川省科技计划项目(No.2021YFSY0048)和中央高校医工结合项目(No.2682021ZTPY015)的支持。
文章链接://doi.org/10.1002/chem.202300785